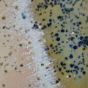
SINTRA - πιάτο πρωινού 22cm, μπλε

SINTRA - πιάτο πρωινού 22cm, μπλε
SINTRA
πιάτο πρωινού 22cm, μπλε
12,99 €
Περιλαμβάνει Φ.Π.Α.
Κωδικός Προϊόντος: 000000001000512758
Ημέρες Παράδοσης: Από 2 εώς 5 εργάσιμες ημέρες
Μοναδικό στυλ στο τραπέζι: το πιάτο πρωινού SINTRA σαγηνεύει με δυναμικές χρωματικές μεταβάσεις κι αφηρημένα μοτίβα. Αυτό το μοναδικό, κεραμικό πιάτο με κρακελέ σμάλτο, αποπνέει μια αίσθηση αυθεντικής, προσγειωμένης πολυτέλειας.
Μοναδικό στυλ στο τραπέζι: το πιάτο πρωινού SINTRA σαγηνεύει με δυναμικές χρωματικές μεταβάσεις κι αφηρημένα μοτίβα. Αυτό το μοναδικό, κεραμικό πιάτο με κρακελέ σμάλτο, αποπνέει μια αίσθηση αυθεντικής, προσγειωμένης πολυτέλειας.